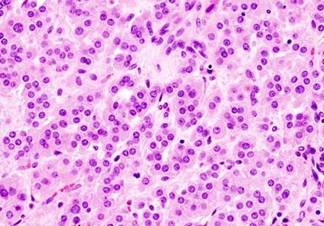

Клинические особенности у больных гормонально-неактивными доброкачественными опухолями надпочечников, подозрительными на АКР
Клинические проявления в виде жалоб на интенсивные боли в пояснич- ной области на стороне поражения отмечены у 3 из 19 больных 3-ей группы. Признаков эндогенного гиперкортизолизма не выявлено ни у одного больного.
Жалобы на общую слабость, нарушения менструального цикла установлены у 1 больной. При детальном опросе болевой синдром на стороне локализации опу- холи был выявлен еще у 3 пациентов, что послужило поводом к целенаправ- ленному выполнению УЗИ брюшной полости и забрюшинного пространства.Клиническое наблюдение №4. Больная В., 48 лет (и.б.№5437-С) поступи- ла в клинику 13.03.2007 года с жалобами на эпизодическое повышение АД, бо- лями в правом подреберье, периодические головные боли. Эпизодическое по- вышение АД отмечала в течении 10 лет до поступления. За 6 месяцев до по- ступления отметила учащение приступов повышения АД с максимальными цифрами систолического АД 190 и диастолического - 100 мм.рт.ст. При обсле- довании в кардиологическом стационаре установлен диагноз: ИБС. ХСН, 2ФК. Гипертоничсекая болезнь 2 стадии. Сердечная недостаточность 2 ФК. При УЗИ органов брюшной полости в проекции правого НП выявлено образование раз- мерами 3,8х2,4 см. Проведена оценка гормонального статуса. Уровень кортизо- ла крови составил 95,1 нг/мл (норма: 20-100), кортизона - 24,7 нг/мл (норма: 10-
30), кортикостерона – 10,4 нг/мл (норма: до 5), дезоксикортикостерона – менее 2 (норма: менее 2), 11-дезоксикортизола менее 2 (норма: менее 2), альдостерона
– 41 пг/мл (норма: 10 -105), ангиотензина 1 – 0,4 нг/мл/ч (норма: 0,5 – 1,9),
АКТГ – 10 пг/мл (норма: 0-50), ДГЭА сульфат – 0,01 мкг/мл (норма: 0,3-3,33), РЭА – 1,21 (норма: 0-4,6). При СКТ органов брюшной полости в проекции пра- вого надпочечника выявлено объемное образование размером 3,0х2,8 см, с не- ровными контурами, неоднородной структуры, плотностью 40HU, которая по- сле внутривенного введения контрастного препарата возрасла до 76HU на 1 минуте после его введения.
АКТГ – 10 пг/мл (норма: 0-50), ДГЭА сульфат – 0,01 мкг/мл (норма: 0,3-3,33), РЭА – 1,21 (норма: 0-4,6). При СКТ органов брюшной полости в проекции пра- вого надпочечника выявлено объемное образование размером 3,0х2,8 см, с не- ровными контурами, неоднородной структуры, плотностью 40HU, которая по- сле внутривенного введения контрастного препарата возрасла до 76HU на 1 минуте после его введения.

Рис. 3.9. Макропрепарат опухоли правого надпочечника больной В.
Рис. 3.10. Аденома правого НП. Окраска гематоксилином и эозином.
Ув.200.
При гистологическом исследовании – аденома коры надпочечника (рис.3.10).
Диагноз: опухоль правого надпочечника (прекортикостерома). Ранний после- операционный период протекал без осложнений. Швы сняты на 8 сутки после операции. Больная выписана из стационара на 9 сутки послеоперационного пе- риода. Наблюдается в течение 7 лет после оперативного лечения – самочув- ствие удовлетворительное, данных за рецидив заболевания нет. В данном наблюдении онкологическая настороженность по риску развития АКР была связана с наличием болевого синдрома, артериальной гипертензии и выявления при КТ опухоли надпочечника с высокой плотностью.
Случайной находкой опухоль надпочечника при скрининговом УЗИ бы- ла у 16 из 19 больных при обследовании по поводу заболеваний органов желу- дочно-кишечного тракта и грудной полости. На этапе оценки клинических про- явлений 6 (31,6%) из 19 больных были включены в контрольную группу паци- ентов с подозрением на АКР. Критерий включения в данную группу – наличие образования в проекции надпочечника и выраженный болевой синдром на сто- роне локализации опухоли.
Остальные 13 больных были включены в группу пациентов с новообразованиями подозрительными на АКР на следующих эта- пах лабораторно-инструментального обследования.Таким образом, проведенный анализ клинических проявлений у больных различными формами АКР показал отсутствие достоверных признаков, позво- ляющих однозначно диагностировать АКР на основе только клинических про- явлений, что вполне согласуется с данными большинства исследователей [112, 118, 137, 159, 189, 228]. Оценка характера клинических проявлений позволило только заподозрить и выделить группу риска больных подозрительных на АКР. Жалобы на боли в животе или поясничной области на стороне расположения выявленной опухоли надпочечника должны вызывать настороженность о воз- можности развития АКР. Однако данное сочетание болевого синдрома и обна- ружение при скрининговом УЗИ опухоли надпочечника не является достовер- ным диагностическим критерием и должно оцениваться в совокупности с дан- ными лабораторных и инструментальных исследований. Возможность типич- ного и нетипичного проявления АКР, а также отсутствие специфических кли-
нических проявлений у больных со случайно выявленными опухолями надпо- чечников на ранних стадиях заболевания так же диктуют необходимость про- ведения специальных лабораторных и инструментальных исследований.
Еще по теме Клинические особенности у больных гормонально-неактивными доброкачественными опухолями надпочечников, подозрительными на АКР:
- 3.2.3. Особенности морфологических изменений надпочечников при АКР
- 3.1. Особенности клинических проявлений у больных адренокортикальным раком
- Доброкачественные опухоли роговицы и лимба
- 4.1.Непосредственные результаты оперативных вмешательств Предоперационная подготовка, проводимая у больных АКР,
- Клиническая характеристика и особенности изменений спектральных показателей вариабельности ритма сердца во время выполнения активной ортостатической пробы у больных с нейрогенными обмороками в межприступном периоде
- Общая клиническая характеристика больных
- Содержание клинической характеристики состояния больного
- 2.1. Клиническая характеристика обследованных больных
- 40. Зависимость нейропсихологического синдрома от характера патологического процесса (опухоль, травма, сосудистое поражение) и возраста больного.
- 3.1.1. Оценка клинических симптомов у больных ХОБЛ и ХОБЛ в сочетании с БА
- Биологические и фенотипические особенности опухолей
- 2.4. особенности реабилитации нервно-психических больных